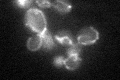
YGR112W
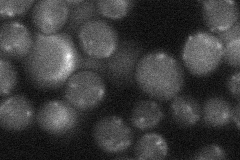
YGR112W

View description
Mitochondrial inner membrane protein required for assembly of cytochrome c oxidase (complex IV); associates with complex IV assembly intermediates and complex III/complex IV supercomplexes; similar to human SURF1 involved in Leigh Syndrome
Localization:
Intensity:
Fold change:
Significance:
-
C’ GFP library in SD
mitochondria27.47 -
N' NOP1pr-GFP in SD

mitochondria44.4144 -
N' TEF2pr-mCherry in SD

ER,punctate0 -
N' NATIVEpr-GFP in SD
punctate22.7254 -
N' TEF2pr-VC and Cyto-VN in SD

#N/A0 -
C’ GFP library in SD+DTT

mitochondria29.141.06No -
C’ GFP library in SD+H2O2

mitochondria33.231.2No -
C’ GFP library in Starvation Media

mitochondria66.922.43Yes -
C’ GFP library on the background of Pup2-DaMP

mitochondria -
C’ GFP library on the background of CCT mutant

mitochondria36.93641.34381No
